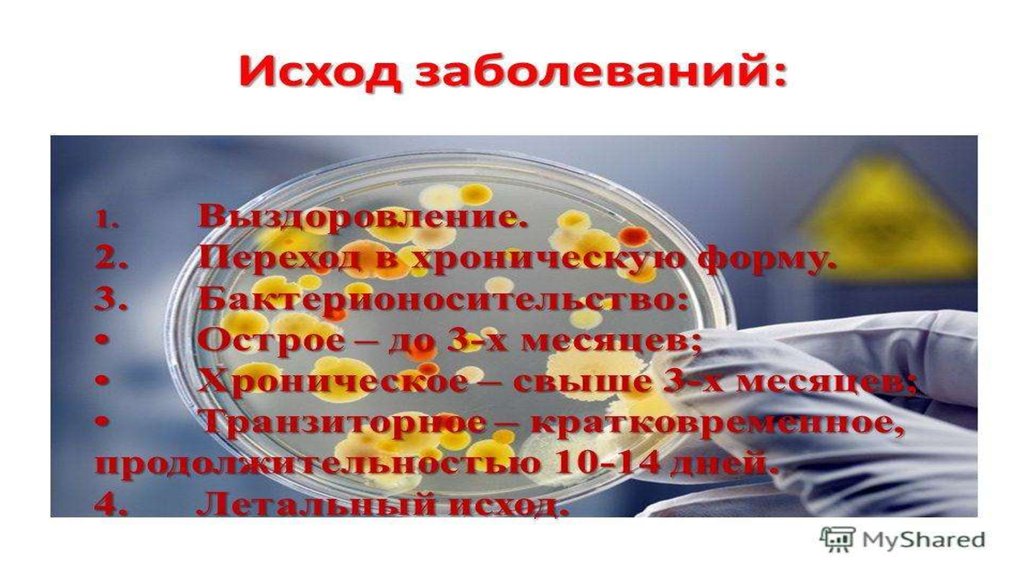

3 исхода болезни
3 исхода болезни 115 фотографий
Агран инструкция по применению отзывы
Скайрим мод тяжелая броня
Дмрв признаки неисправности шевроле
Илан маск
Callapp что это
Отключается интернет каждые 5 минут
Ул блюхера 24
Возврат аванса от нерезидента код валютной операции
Орбита ул руставели 59е
Мгту гражданской авиации москва